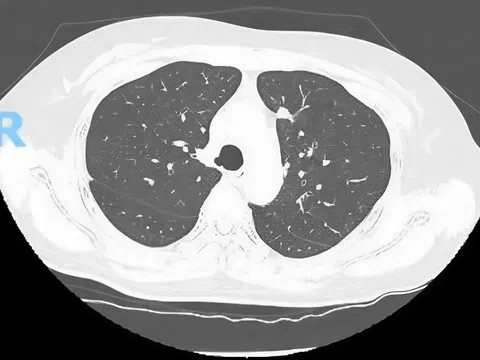

Cuộc sống vật chất ngày càng đầy đủ, chế độ ăn uống thiếu cân bằng, sử dụng nhiều đồ ăn nhanh, đồ ngọt, ít vận động… khiến tỷ lệ trẻ thừa cân, béo phì ngày càng gia tăng.
Béo phì ảnh hưởng thế nào đến chiều cao của trẻ?
Thừa cân, béo phì là tình trạng tích tụ mỡ quá mức trong cơ thể, gây ảnh hưởng tiêu cực đến sức khỏe. Tổ chức Y tế Thế giới (WHO) cho biết, tình trạng này đang có xu hướng tăng nhanh ở trẻ em. Theo tiêu chuẩn, một bé gái 5 tuổi có cân nặng trung bình khoảng 15,8–21,2 kg. Nếu cao 1,06 m nhưng nặng 27 kg thì đã được xếp vào nhóm thừa cân.
Không phải mọi trẻ béo phì đều bị hạn chế chiều cao, tuy nhiên, quá trình tăng trưởng của trẻ thường bị ảnh hưởng do rối loạn nội tiết và áp lực lên hệ xương.
Trẻ béo phì thường có chiều cao vượt trội trong giai đoạn đầu (trước tuổi dậy thì), nhưng sau đó tốc độ phát triển chậm lại, thậm chí ngừng sớm. Nguyên nhân là hormone leptin trong mô mỡ kích thích dậy thì sớm, khiến các đầu xương đóng sớm hơn bình thường, hạn chế chiều cao tối đa.
Ngoài ra, trọng lượng cơ thể lớn gây áp lực lên xương, khớp, khiến xương dễ tổn thương và kém phát triển. Trẻ béo phì cũng dễ gặp các rối loạn chuyển hóa như tăng mỡ máu, xơ vữa động mạch, tăng huyết áp, ngưng thở khi ngủ, ngủ ngáy hoặc mệt mỏi ban ngày.
![]() |
Không chỉ ảnh hưởng đến chiều cao, béo phì còn làm tăng nguy cơ mắc các bệnh mạn tính như tăng huyết áp,... |
Một trong những hệ quả phổ biến nhất của béo phì là dậy thì sớm - đặc biệt ở bé gái. Dù trẻ có thể cao nhanh lúc đầu, nhưng việc các tấm sụn tăng trưởng đóng sớm sẽ khiến chiều cao tối đa bị giới hạn khi trưởng thành.
Béo phì còn làm rối loạn hormone tăng trưởng (GH) và IGF-1 - hai yếu tố quan trọng giúp xương dài ra. Khi nồng độ insulin và leptin tăng cao, sự tiết GH bị ức chế, dẫn đến giảm tốc độ phát triển chiều cao. Ngoài ra, chứng ngưng thở khi ngủ do tích mỡ quanh cổ họng khiến trẻ khó đạt được giấc ngủ sâu, làm giảm tiết GH – vốn đạt đỉnh vào ban đêm từ 22h-2h sáng.
Không chỉ ảnh hưởng đến chiều cao, béo phì còn làm tăng nguy cơ mắc các bệnh mạn tính như tăng huyết áp, tiểu đường, mỡ máu, đột quỵ, đau khớp, trầm cảm, lo âu, thậm chí ung thư.
Các nghiên cứu cho thấy, thừa cân ở giai đoạn 2–8 tuổi có thể khiến trẻ dậy thì sớm hơn, làm giảm chiều cao cuối cùng khi trưởng thành. Cụ thể, mỗi đơn vị BMI tăng trong giai đoạn này có thể khiến chiều cao giảm 0,88 cm ở bé trai và 0,51 cm ở bé gái.
Phòng tránh béo phì, tăng chiều cao tối ưu cho trẻ
- Xây dựng chế độ ăn khoa học
Hạn chế đồ ngọt, tinh bột tinh chế, thức ăn nhanh, nước ngọt có gas. Tăng cường rau xanh, trái cây tươi, thịt nạc, cá, trứng và sữa ít béo. Ưu tiên bổ sung canxi, vitamin D, protein và kẽm – các dưỡng chất giúp phát triển xương. Chia nhỏ bữa ăn trong ngày, không bỏ bữa sáng, tránh ăn tối sau 19h30.
- Duy trì vận động thể chất mỗi ngày
Thiết lập thói quen vận động giúp trẻ kiểm soát cân nặng và phát triển chiều cao. Trong quá trình vận động, các hormone tăng trưởng được kích thích, hỗ trợ xương phát triển tốt hơn.
Tập luyện ít nhất 60 phút/ngày, ưu tiên các môn kéo giãn và chịu lực như bơi, bóng rổ, nhảy dây, đi bộ nhanh. Với trẻ thừa cân nhiều, nên bắt đầu bằng đi bộ, đạp xe, yoga hoặc bơi để giảm áp lực lên khớp. Hạn chế thời gian xem tivi, chơi điện tử, dùng điện thoại – tối đa 2 giờ/ngày.
- Ngủ đủ và đúng giờ
Giấc ngủ là yếu tố quyết định trong quá trình phát triển chiều cao. Cho trẻ ngủ trước 22h, đảm bảo 8–10 tiếng mỗi đêm. Tránh sử dụng thiết bị điện tử ít nhất 1 giờ trước khi ngủ. Giữ phòng ngủ yên tĩnh, tối, thoáng mát để giúp trẻ ngủ sâu hơn.
Trẻ em không phải sinh ra đã khỏe mạnh về cảm xúc, trẻ phải được tôi luyện. Trẻ cần được nuôi dưỡng và dạy bảo các kỹ năng xác định cảm xúc của mình và thể hiện ra theo cách tích cực, từ đó, trẻ có thể kết nối với những người khác theo cách thông minh về cảm xúc.
Cuốn sách Đứa trẻ khỏe mạnh về cảm xúc mang tới cái nhìn toàn diện hơn về vai trò của việc giáo dục trong quá trình định hình tính cách của con trẻ. Trong hành trình nuôi dưỡng một đứa trẻ việc xây dựng một thế giới tinh thần phong phú, quan trọng không kém gì quá trình phát triển về thể chất tới cho các bà mẹ nhiều kiến thức hữu ích trong năm đầu nuôi con.